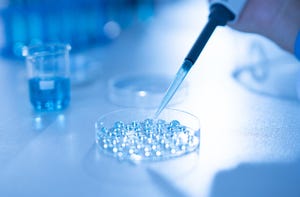
Fertility: How IVF Patients Turn to AI for Guidance and Caution

Anthropic announced Claude for Healthcare, a suite of AI tools aimed at providers, payers, and patients. Like OpenAI’s ChatGPT Health, the platform can sync health data from phones and wearables without using that data for model training. Claude adds advanced "connectors" to major medical databases such as the CMS Coverage Database, ICD-10, the National Provider Identifier Standard, and PubMed, enabling faster prior‑authorization reviews and research. While industry observers note the risk of hallucination‑prone large language models offering medical advice, both Anthropic and OpenAI caution users to consult qualified healthcare professionals.
Leia mais →